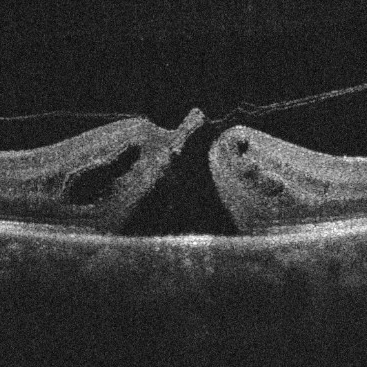

Description
This package includes an ultrawide field image (UWF) of the retina and an OCT scan of the macula. Consultation not included.
Retina Assessment
Details
MUR 4,500
About us
Who we are
We offer comprehensive clinical ophthalmology with surgical expertise in cataract and vitreoretinal disorders. Our patients, from Mauritius and beyond, enjoy personalised, world-class care delivered by caring, compassionate professionals using state-of-the-art technology.
Address
22 Enniskillen Street , Port Louis
Opening hours
Monday
8:00 am – 5:00 pm
Tuesday
8:00 am – 5:00 pm
Wednesday
8:00 am – 5:00 pm
Thursday
8:00 am – 5:00 pm
Friday
8:00 am – 5:00 pm
Saturday
Closed
Sunday
Closed